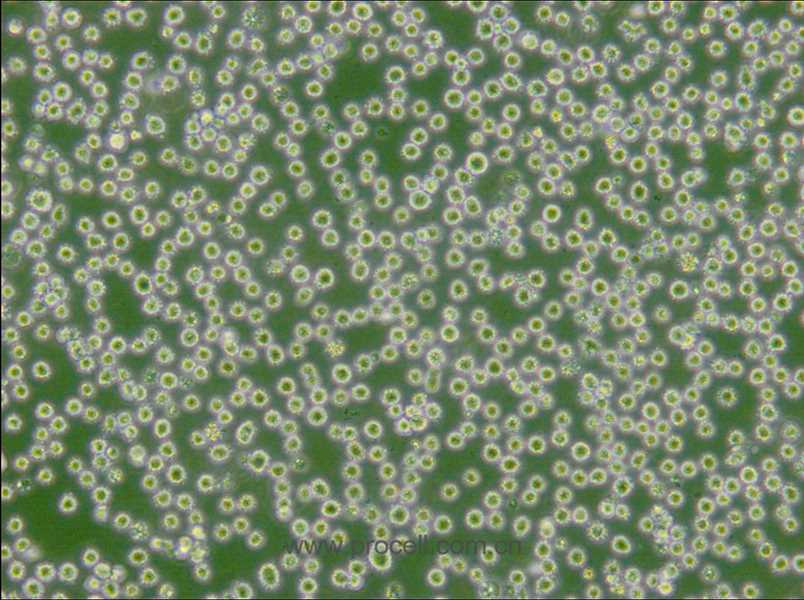
DB (彌漫大B細(xì)胞淋巴瘤細(xì)胞) (STR鑒定正確)
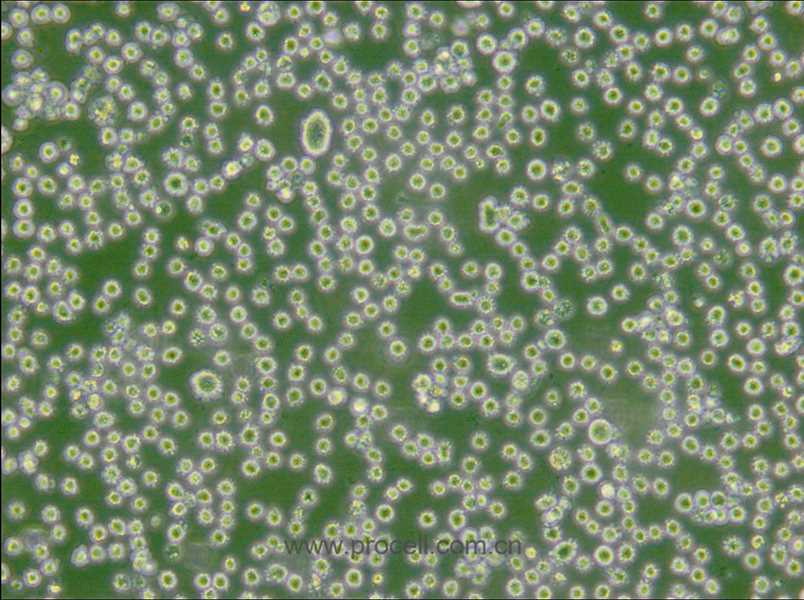
DB (彌漫大B細(xì)胞淋巴瘤細(xì)胞) (STR鑒定正確)
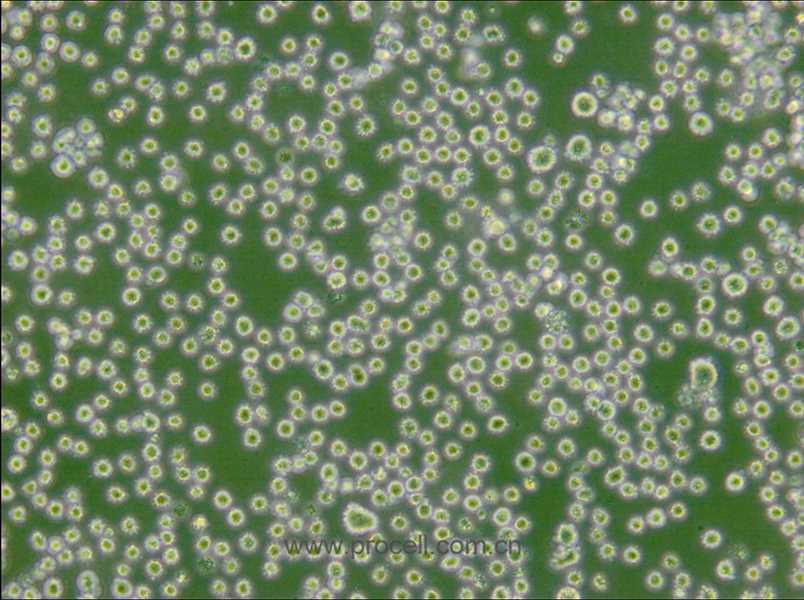
DB (彌漫大B細(xì)胞淋巴瘤細(xì)胞) (STR鑒定正確)

產(chǎn)品中心Cell Resources
聯(lián)系我們CONTACT US
400-999-210024小時服務(wù)熱線
產(chǎn)品概述
| 名稱 | DB (彌漫大B細(xì)胞淋巴瘤細(xì)胞) (STR鑒定正確) |
| 種屬 | 人 |
| 生長特性 | 懸浮細(xì)胞 |
| 細(xì)胞形態(tài) | 淋巴母細(xì)胞 |
| 凍存條件 | 凍存液:55% 基礎(chǔ)培養(yǎng)基+40%FBS+5%DMSO 溫度:液氮 |
| 培養(yǎng)方案A(默認(rèn)) |
培養(yǎng)條件:
氣相:空氣,95%;CO2,5%, 溫度:37℃
|
| 推薦傳代比例 | 2×10^5-5×10^5cells/mL |
| 推薦換液頻率 | 2-3次/周 |
| 注意事項 | 該細(xì)胞為懸浮細(xì)胞,請注意離心收集細(xì)胞懸液;請勿直接倒掉細(xì)胞培養(yǎng)液。 |
| 年齡(性別) | 男性;45歲 |
| 組織來源 | 腹水 |
| 細(xì)胞類型 | 腫瘤 |
| 腫瘤類型 | 淋巴瘤細(xì)胞 |
STR鑒定
-
STR位點(diǎn)信息
Amelogenin X,Y CSF1PO 10,11 D2S1338 18,24 D3S1358 18 D5S818 11 D7S820 11 D8S1179 13,14 D13S317 11,12 D16S539 11 D18S51 15 D19S433 11,13 D21S11 29,31.2 FGA 22 PentaD 9,12 PentaE 10 TH01 6,8 TPOX 8 vWA 15,16 D6S1043 12 D12S391 17 D2S441 14 -
STR鑒定圖
-
參考文獻(xiàn)
-
Comprehensive analysis of the prognostic implication and immune infiltration of CISD2 in diffuse large B-cell lymphoma(2023/12/12)
作者:ChaoFeng Zhang, Qi Lin, ChunTuan Li
期刊:Frontiers in Immunology
DOI:10.3389/fimmu.2023.1277695
影響因子 :7.300
引用產(chǎn)品:CL-0645
-
Anti-CD79b/CD3 bispecific antibody combined with CAR19-T cells for B-cell lymphoma treatment(2023/09/14)
作者:Weiwei Zheng, Hang Zhou, Ping Li
期刊:CANCER IMMUNOLOGY IMMUNOTHERAPY
DOI:10.1007/s00262-023-03526-z
影響因子 :5.800
-
A miR-129-5P/ARID3A Negative Feedback Loop Modulates Diffuse Large B Cell Lymphoma Progression and Immune Evasion Through Regulating the PD-1/PD-L1 Checkpoint(2021/10/27)
作者:Weili Zheng, Guilan Lai, Qiaochu Lin
期刊:Frontiers in Cell and Developmental Biology
影響因子 :5.500
引用產(chǎn)品:CL-0645
-
FKBP3 aggravates the malignant phenotype of diffuse large B-cell lymphoma by PARK7-mediated activation of Wnt/β-catenin signalling(2023/11/21)
作者:Xiaojing Xing, Meichen Liu, Xuguang Wang
期刊:JOURNAL OF CELLULAR AND MOLECULAR MEDICINE
影響因子 :5.300
引用產(chǎn)品:CL-0645
-
Targeting HDACs for diffuse large B-cell lymphoma therapy(2024/01/02)
作者:Chunyan Wu, Qiao Song, Sophie Gao
期刊:Scientific Reports
DOI:10.1038/s41598-023-50956-x
影響因子 :4.600
引用產(chǎn)品:CL-0645
-
Promoting effects of calponin 3 on the growth of diffuse large B?cell lymphoma cells(2023/01/13)
作者:Xiaojing Xing, Meichen Liu, Xuguang Wang
期刊:ONCOLOGY REPORTS
影響因子 :4.200
引用產(chǎn)品:CL-0645
-
Identification of PLA2G7 as a novel biomarker of diffuse large B cell lymphoma(2021/08/17)
作者:Weili Zheng, Qiaochu, Issah
期刊:Bmc Cancer
DOI:10.1186/s12885-021-08660-4
影響因子 :3.800
引用產(chǎn)品:CL-0645
-
Chidamide and orelabrutinib synergistically induce cell cycle arrest and apoptosis in diffuse large B-cell lymphoma by regulating the PI3K/AKT/mTOR pathway(2024/02/21)
作者:Chunyan Wu, Shilv Chen, Zhimin Wu
期刊:JOURNAL OF CANCER RESEARCH AND CLINICAL ONCOLOGY
DOI:10.1007/s00432-024-05615-7
影響因子 :3.600
引用產(chǎn)品:CL-0645
-
Ras interacting protein 1 facilitated proliferation and invasion of diffuse large B-cell lymphoma cells(2023/03/26)
作者:Xiaojing Xing, Xuguang Wang, Meichen Liu
期刊:CANCER BIOLOGY & THERAPY
DOI:10.1080/15384047.2023.2193114
影響因子 :3.600
引用產(chǎn)品:CL-0645
-
MiR-665 suppresses the progression of diffuse large B cell lymphoma (DLBCL) through targeting LIM and SH3 protein 1 (LASP1)(2021/11/29)
作者:Yan Wang, Dongmei Guo, Banban Li
期刊:Leukemia Research
DOI:10.1016/j.leukres.2021.106769
影響因子 :2.700
FAQs
Q:{{item.question}}
A:
產(chǎn)品資料
識別碼示意圖

![NCI-H2452 [H2452] (人間皮瘤細(xì)胞) (STR鑒定正確)](/Public/upfile/pic/xbx/CL-0398-1.jpg)











